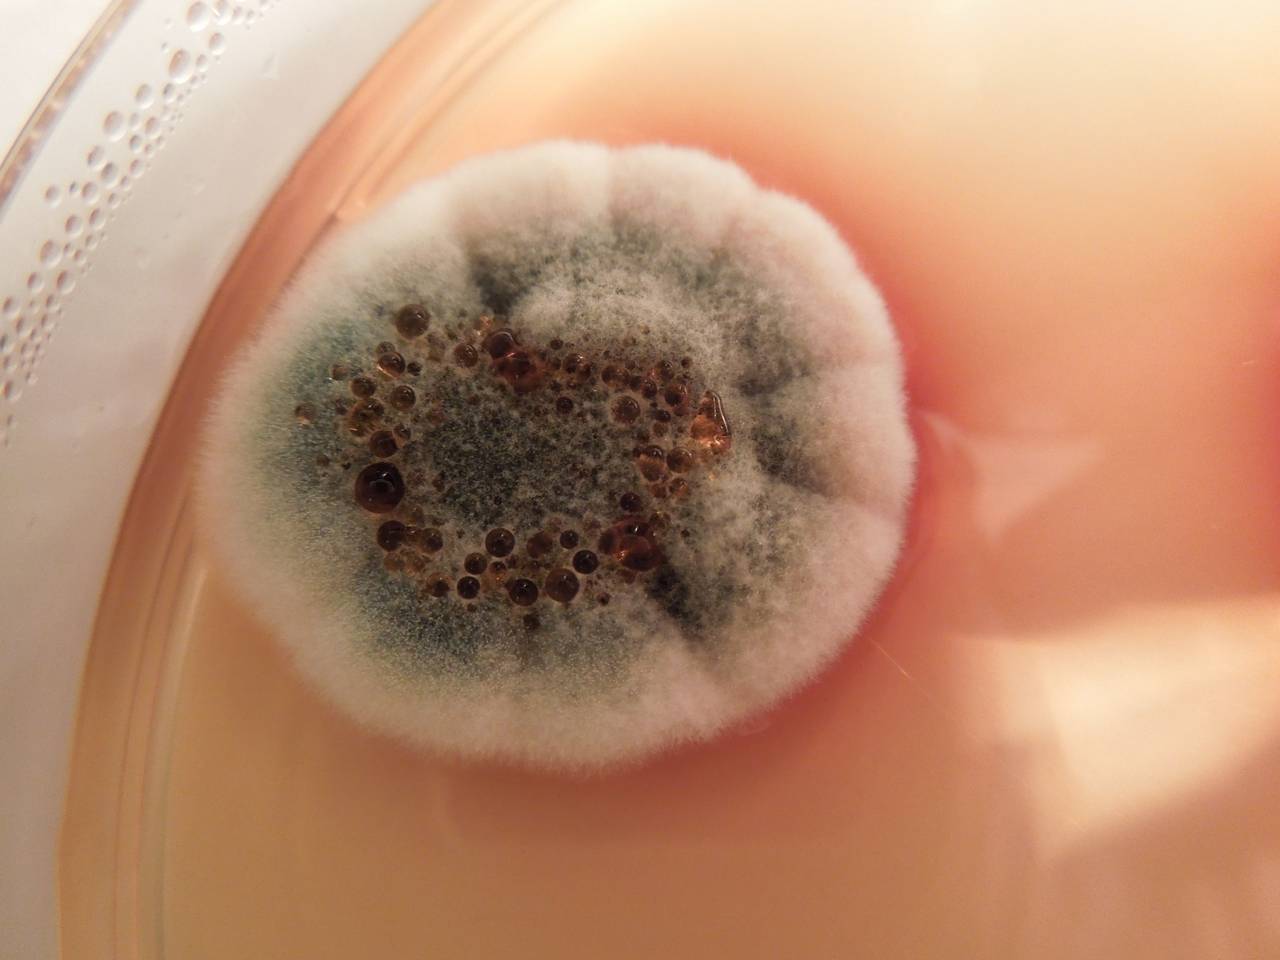

Грибок В Ушах Фото
Грибок В Ушах Фото 138 фотографий
Рисунок Лиса На Ногтях Фото
Фото Карпа На Траве
Фотографии Михаила Булгакова
Сейлормун Картинки На Аву
Коралловые Губы Татуаж Фото
Маленькие На Пляже Фото
Фото Самого Маленького Животного
Екатерина Шарапова 1970 1997 Екатеринбург Фото
Салат Гнездо Глухаря С Курицей Фото
Купе Со Вставками Фото